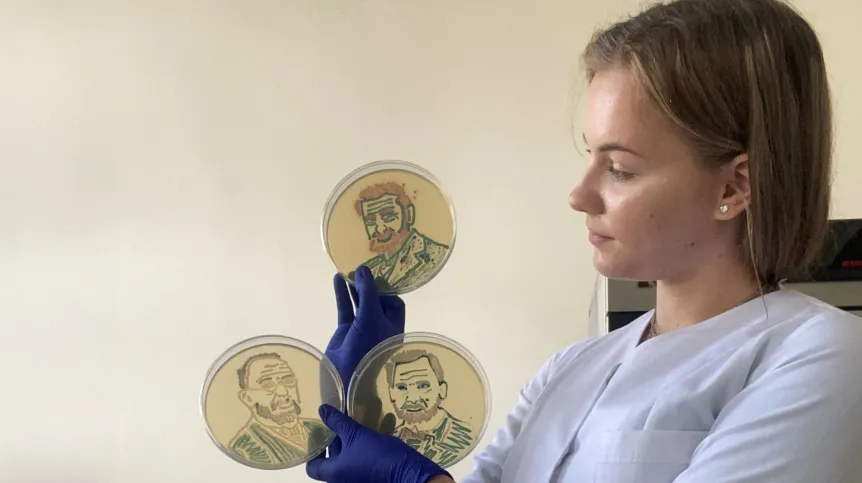
Fot. Uniwersytet Przyrodniczy w Poznaniu

Zamiast farb ma paletę z bakteriami, zamiast pędzla – ezę, czyli przyrząd używany w laboratoriach. Studentka weterynarii na Uniwersytecie Przyrodniczym w Poznaniu Martyna Pietrzak maluje obrazy wykorzystując do tego różne gatunki bakterii.
Studentka trzeciego roku kierunku weterynaria na Uniwersytecie Przyrodniczym w Poznaniu Martyna Pietrzak stworzyła portrety najwybitniejszych mikrobiologów: Roberta Kocha, Louisa Pasteura oraz Odo Bujwida, polskiego mikrobiologa, ucznia Kocha, a prywatnie ojca pierwszej kobiety lekarza weterynarii, Heleny Jurgielewiczowej. Portrety zostały namalowane różnymi gatunkami bakterii, których bank jest tworzony przez prof. UPP dr hab. Agnieszkę Pękalę-Safińską z Katedry Nauk Przedklinicznych i Chorób Zakaźnych Wydziału Medycyny Weterynaryjnej i Nauk o Zwierzętach UPP.
Pietrzak w rozmowie z PAP przyznała, że zainteresowała się tym rodzajem sztuki przypadkiem. Jak mówiła, pewnego wieczoru siedząc na kanapie szukała w internecie informacji o „mikrobiologii art” i w wyszukiwarce zaczęły się jej pojawiać kolorowe obrazy, do których zamiast farb – używa się żywych bakterii. Zwróciła się wtedy do prof. UPP dr hab. Agnieszki Pękali-Safińskiej i postanowiła wziąć udział w międzynarodowym konkursie Agar Art organizowanym przez Amerykańskie Towarzystwo Mikrobiologiczne. To właśnie na potrzeby konkursu stworzone zostały przez nią portrety wybitnych mikrobiologów.
Pietrzak pytana przez PAP, czy „mikrobiologia art” to „niebezpieczny rodzaj sztuki” powiedziała, że bardzo istotne przy tym „malowaniu” są środki ostrożności.
„Praca musi być wykonywana w specjalnym laboratorium. Ja malowałam i pracowałam cały czas także pod nawiewem, aby te bakterie, które np. wytwarzają przetrwalniki, żeby one się nie rozprzestrzeniały. Później oczywiście wszystko trzeba było odpowiednio dezynfekować, używać lamp UV, rękawiczek, maseczki, fartucha, mieć też związane włosy, by nic przypadkowo się nie przeniosło. Ważna też była przede wszystkim taka uważność, by tą ezą, czyli tym moim pędzlem, nie dotknąć niepotrzebnie jakichś rzeczy czy siebie, żeby tych bakterii nigdzie nie przenieść” – powiedziała.
Dodała, że łącznie praca nad jej dziełem trwała około roku. Jak tłumaczyła, „w tym czasie trzeba było przede wszystkim wybrać bakterie z banku szczepów bakteryjnych, który na Uniwersytecie Przyrodniczym tworzy prof. UPP dr hab. Agnieszka Pękala-Safińska, i trzeba było dokonać tego wyboru tak, aby - jeśli się użyje pewnych bakterii z innymi bakteriami – one się nie rozrosły i nie zajęły całej płytki”.
„Niektóre z tych portretów są namalowane bakteriami uzyskanymi od ryb, niektóre są bakteriami ssaczymi. Trzeba więc było je posiać, zidentyfikować, potem je ożywić, wybrać odpowiednie podłoże, aby uzyskać odpowiedni kolor – bo to nie jest tak, że te bakterie mają jakiś kolor. One dopiero pod wpływem podłoża - a dokładnej substancji zawartych w tym podłożu, które bakterie wykorzystują w swoim metabolizmie np. podczas rozkładu danego cukru, wytwarzają kolor” – wskazała.

Pietrzak zaznaczyła, że ostateczny etap wyglądał podobnie, jak przy tworzeniu każdego innego dzieła sztuki. „Miałam już wybraną paletę bakterii, każdą nanosiłam na podłoże osobną ezą, żeby nie doszło do +rywalizacji+ między bakteriami i po namalowaniu odczekałam 24 godziny – bo trzeba to było włożyć do cieplarki, do odpowiedniej temperatury - i następnego dnia otrzymywałam efekty, czyli gotowe dzieło” – mówiła.
Studentka Uniwersytetu Przyrodniczego w Poznaniu została zakwalifikowana do konkursu Agar Art organizowanego przez Amerykańskie Towarzystwo Mikrobiologiczne jako jedna z 85 osób i zarazem jedyna z Polski. Etap głosowania w konkursie trwa do 18 listopada; oprócz nagrody głównej, przyznawana jest również nagroda publiczności. Na prace Martyny Pietrzak można oddać głos za pośrednictwem strony: https://www.flickr.com/photos/193578416@N07/52473235000/in/album-72177720303373347/ . Należy zarejestrować się na platformie Flickr i zaznaczyć gwiazdkę przy pracy
“How did I meet Odo Feliks Kazimierz Bujwid (artist = Martyna Pietrzak)”.
PAP - Nauka w Polsce, Anna Jowsa
ajw/ ekr/
Fundacja PAP zezwala na bezpłatny przedruk artykułów z Serwisu Nauka w Polsce pod warunkiem mailowego poinformowania nas raz w miesiącu o fakcie korzystania z serwisu oraz podania źródła artykułu. W portalach i serwisach internetowych prosimy o zamieszczenie podlinkowanego adresu: Źródło: naukawpolsce.pl, a w czasopismach adnotacji: Źródło: Serwis Nauka w Polsce - naukawpolsce.pl. Powyższe zezwolenie nie dotyczy: informacji z kategorii "Świat" oraz wszelkich fotografii i materiałów wideo.